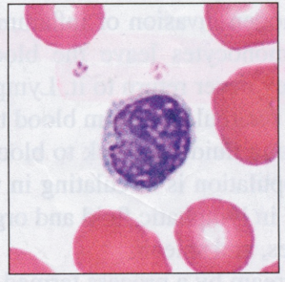
<p>Cells are classified as small (5-8 um), medium (10-12 um), or large (14-17 um); characterized by a realtively large, round, dark-staining nucleus surrounded by a narrow rim of cytoplasm</p>

1/33
Looks like no tags are added yet.
Name | Mastery | Learn | Test | Matching | Spaced | Call with Kai |
|---|
No analytics yet
Send a link to your students to track their progress
Hemoglobin
Protein within red blood cells that aids in the transportation of oxygen, some carbon dioxide; production of this protein requires iron
Plasma
One component of blood; the non-living liquid portion
Formed elements
One of the components of blood; consist of erythrocytes, leukocytes, and platelets
Identify: Lymphocytes
Cells are classified as small (5-8 um), medium (10-12 um), or large (14-17 um); characterized by a realtively large, round, dark-staining nucleus surrounded by a narrow rim of cytoplasm
Type: Lymphocytes
Agranular
Function: Lymphocytes
Give rise to antibody-productin cells (B-cells); directly attack virus-infected cells, transplanted cells, cancer cells, some bacteria (T-cells); increase in number following infection and immune response
Abundance: Lymphocytes
25-35%
Identify: Monocytes
Largest of all WBCs, up to 20 um; characterized by an oval or kindey bean-shaped nucleus surrounded by a pale cytoplasm

Type: Monoctyes
Agranular
Function: Monocytes
Once they leave the capillaries these cells transform into wandering macrophages; macrophages phagocytize pathogens and dead tissue
Abundance: Monocytes
3-7%
Identify: Neutrophils
"“Polymorphonuclear”: nucleus shows a variety of forms, but generally consist of 3 to 5 irregularly oval-shaped lobed connected by thin strands of nuclear material; cytoplasm is filled with very fine granules

Type: Neutrophils
Granular
Function: Neutrophils
Destroy bacteria by phagocytosis (primary); chemically attracted to sites of inflammation
Abundance: Neutrophils
55-65%
Identify: Eosinophils
Characterized by an irregularly shaped nucleus partially contricted into two lobes, somewhat larger than neutrophils; cytoplasm is filled w/ coarse, round uniformly-sized red-orange granules

Type: Eosinophils
Granular
Function: Eosinophils
Targets certain parasitic worms: gather around worm, and releases digestive chemicals from granules; also has a complex role in allergic responses and asthma
Abundance: Eosinophils
1-3%
Identify: Basophils
Contain an irregularly shaped nucleus which may appear as two lobes; cytoplasm is filled w/ irregular, blue-purple granules that usually obscure the bi-lobed nucleus

Type: Basophils
Granular
Function: Basophils
Involved in inflammatory and allergic reactions: release histamine; counts increase w/ allergic reactions, leukemia, diabetes, and autoimmunce disorders
Abundance: Basophils
0.5-1%
Hemocytoblast
Stem cell that resides in the red bone marrow that develops into all formed elements
Hematopoiesis/Hemopoiesis
The process of differentiation from a hemocytoblast to a specific formed element
Platelets
Fragments of cells, broken off from large parent cells (known as megakaryocytes) in the bone marrow and are essential in the process of blood clotting
Anemia
Decrease in oxygen carrying capacity of blood; can result from either low hemoglobin concentration or low erythrocyte count
Aplastic anemia
caused by failure of red bone marrow to produce RBC’s
Iron deficiency anemia
Decrease in hemoglobin production due to inadequate iron; identified by the ratio of hemoglobin to hematocrit
Sickle cell anemia
Inherited condition in which hemoglobin is misshapen, resulting in masshaped RBC and reduced oxygen carrying capacity
Polycythemia
Higher than normal volume of RBC’s
Leukemia
An abnormal increase in the production and release of immature leukocytes by cancerous bone marrow cells
Hematocrit
Packed cell volume (PCV) represente the relative colume of plasma and RBC’s
Buffy coat
White layer that develops during centrifugation to determine hematocrit